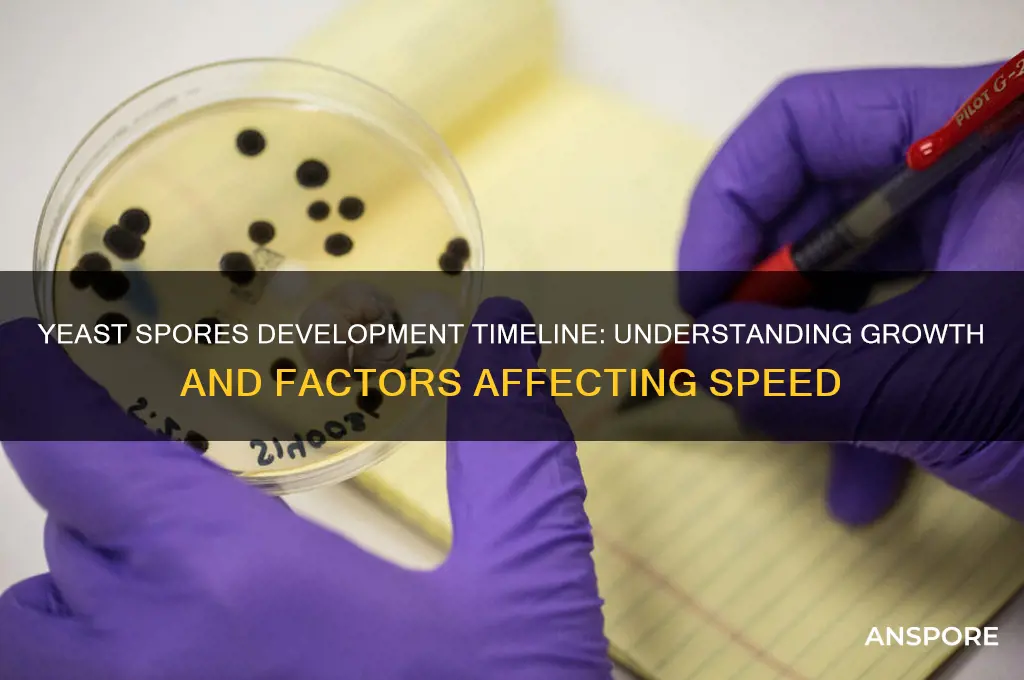
how long does it take yeast spores to develop

Yeast spores, also known as yeast cells in their dormant state, play a crucial role in various industries, including baking, brewing, and biotechnology. Understanding the development time of yeast spores is essential for optimizing processes that rely on yeast fermentation. The time it takes for yeast spores to develop into active, reproducing cells depends on several factors, including the yeast species, environmental conditions such as temperature and nutrient availability, and the presence of stressors like preservatives or high sugar concentrations. Generally, under ideal conditions, yeast spores can germinate and begin active growth within a few hours, with the entire process from spore to mature cell taking anywhere from 6 to 24 hours. However, in less favorable environments, this timeline can be significantly extended, highlighting the importance of controlling conditions to ensure efficient yeast development.
| Characteristics | Values |
|---|---|
| Development Time | 12-18 hours under optimal conditions (25-30°C, nutrient-rich medium) |
| Optimal Temperature Range | 25-30°C (77-86°F) |
| Minimum Temperature for Growth | 10°C (50°F) |
| Maximum Temperature for Growth | 37°C (98.6°F) |
| pH Range for Optimal Growth | 4.0-6.0 |
| Nutrient Requirements | Carbohydrates (e.g., glucose), nitrogen sources, vitamins, minerals |
| Oxygen Requirement | Facultative anaerobe (can grow with or without oxygen) |
| Germination Time | 1-2 hours after exposure to favorable conditions |
| Sporulation Time | 8-12 hours (formation of new spores under stress conditions) |
| Common Yeast Species | Saccharomyces cerevisiae, Candida albicans |
| Inhibiting Factors | High salt concentration, extreme pH, lack of nutrients, antimicrobials |
| Applications | Baking, brewing, biotechnology, scientific research |
Explore related products
What You'll Learn

Optimal Temperature Range for Yeast Sporulation
Yeast sporulation is a critical process influenced significantly by temperature, which acts as a catalyst for the transformation of yeast cells into spores. The optimal temperature range for this process typically falls between 25°C to 30°C (77°F to 86°F), depending on the yeast species. At these temperatures, yeast cells are most likely to initiate sporulation, a survival mechanism triggered by nutrient deprivation. For example, *Saccharomyces cerevisiae*, a common baker’s yeast, sporulates most efficiently within this range, with sporulation rates peaking around 28°C (82.4°F). Temperatures outside this window can either delay or inhibit sporulation entirely, underscoring the importance of precise temperature control in laboratory and industrial settings.
Achieving the optimal temperature range requires careful monitoring and adjustment, especially in controlled environments like bioreactors or incubators. For home fermenters or small-scale experiments, maintaining a stable temperature can be as simple as using a heating pad or placing the culture in a temperature-controlled room. However, even minor fluctuations can disrupt the process. For instance, temperatures above 35°C (95°F) can denature essential enzymes involved in sporulation, while temperatures below 20°C (68°F) slow metabolic activity, prolonging the time required for spore development. Practical tips include using thermometers or digital temperature controllers to ensure consistency, particularly during the critical early stages of sporulation.
Comparatively, different yeast species exhibit varying temperature preferences for sporulation, highlighting the need for species-specific approaches. While *S. cerevisiae* thrives at 28°C, other species like *Schizosaccharomyces pombe* may require slightly lower temperatures, around 25°C (77°F). This variability necessitates research into the specific needs of the yeast strain in use. For instance, in winemaking, where yeast sporulation can impact fermentation, winemakers often adjust temperatures based on the yeast’s sporulation profile to optimize flavor and alcohol content. Understanding these nuances allows for tailored temperature management, ensuring efficient and timely spore development.
From a persuasive standpoint, investing in temperature control equipment is not just a luxury but a necessity for anyone serious about yeast sporulation. Whether for scientific research, brewing, or baking, the return on investment is evident in the consistency and quality of results. For example, a ±1°C temperature control system can reduce sporulation time by up to 20%, significantly improving productivity. Additionally, precise temperature management minimizes the risk of contamination or failed batches, which can be costly in industrial settings. By prioritizing temperature optimization, practitioners can unlock the full potential of yeast sporulation, turning a biological process into a predictable and efficient workflow.
In conclusion, mastering the optimal temperature range for yeast sporulation is both an art and a science. It demands attention to detail, species-specific knowledge, and the right tools. Whether working with *S. cerevisiae* at 28°C or another strain at a slightly different temperature, the goal remains the same: creating conditions that encourage rapid and successful spore development. By adhering to these guidelines, practitioners can streamline their processes, reduce variability, and achieve consistent results, making temperature control a cornerstone of effective yeast sporulation.
Dyson Purifier vs. Mold Spores: Can It Effectively Combat Growth?
You may want to see also

Impact of Nutrient Availability on Development Time
Yeast spores, or ascospores, germinate and develop into viable cells within 2–4 hours under optimal conditions, but nutrient availability can significantly alter this timeline. When nutrients are abundant, yeast cells prioritize rapid growth and division, shortening development time. For instance, a medium rich in glucose (2% concentration) and nitrogen sources like ammonium sulfate (0.5%) can accelerate germination by providing the energy and building blocks needed for cellular processes. Conversely, nutrient scarcity extends development time, as cells divert resources to survival mechanisms rather than reproduction.
Consider a practical scenario: in winemaking, nutrient-poor grape musts often delay yeast fermentation, leading to stuck fermentations. Winemakers address this by adding diammonium phosphate (DAP) at a rate of 20–30 mg/L during the initial stages, ensuring yeast cells have sufficient nitrogen to thrive. This intervention reduces development time from 12–24 hours to 4–6 hours, demonstrating the direct correlation between nutrient availability and growth efficiency.
Analyzing the mechanism, nutrient availability influences key metabolic pathways. Adequate sugars (e.g., glucose or fructose) fuel glycolysis, producing ATP and NADH essential for cellular functions. Similarly, nitrogen sources like amino acids and ammonium ions are critical for protein synthesis and DNA replication. Without these, yeast cells enter a quiescent state, delaying spore development by up to 48 hours. For laboratory cultures, supplementing media with yeast extract (1%) and peptone (2%) ensures balanced nutrient availability, optimizing development time.
A comparative study highlights the impact of nutrient gradients. In a gradient of glucose concentrations (0.5% to 4%), yeast spores exposed to 4% glucose germinated 50% faster than those in 0.5% glucose. However, excessively high nutrient levels (e.g., 10% glucose) can inhibit growth due to osmotic stress, proving that moderation is key. This principle applies to homebrewers, who should avoid overfeeding yeast with sugars to prevent sluggish fermentation.
In conclusion, nutrient availability acts as a throttle for yeast spore development, dictating whether cells thrive or struggle. By understanding this relationship, industries from baking to biotechnology can manipulate nutrient levels to control development time effectively. For optimal results, maintain a balanced nutrient profile, monitor environmental conditions, and adjust dosages based on specific yeast strains and applications.
Can Filtration Effectively Eliminate Spores? Exploring Methods and Limitations
You may want to see also

Role of pH Levels in Sporulation Speed
Yeast sporulation is a complex process influenced by various environmental factors, with pH levels playing a pivotal role in determining the speed and efficiency of spore development. The optimal pH range for yeast sporulation typically falls between 3.5 and 5.5, as this slightly acidic environment mimics the natural conditions in which yeast thrives. Outside this range, sporulation rates can significantly decline, with extreme pH levels inhibiting the process altogether. For instance, a pH below 3.0 or above 7.0 can halt sporulation, as these conditions disrupt the cellular mechanisms necessary for spore formation.
To manipulate sporulation speed, researchers and brewers often adjust pH levels strategically. For example, in the brewing industry, maintaining a pH of 4.5–5.0 during the fermentation process can encourage yeast to sporulate more rapidly, which is beneficial for producing certain types of beer with unique flavor profiles. Conversely, in laboratory settings, scientists might lower the pH to 3.5 to study stress-induced sporulation, as yeast often forms spores as a survival mechanism in harsh conditions. Practical tips include using food-grade acids like lactic or acetic acid to lower pH gradually, ensuring the change does not shock the yeast cells.
A comparative analysis reveals that different yeast strains respond variably to pH changes. For instance, *Saccharomyces cerevisiae*, commonly used in baking and brewing, sporulates most efficiently at pH 4.0–4.5, while *Schizosaccharomyces pombe* prefers a slightly higher pH of 5.0–5.5. This strain-specific sensitivity underscores the importance of tailoring pH adjustments to the yeast species in use. Additionally, the age of the yeast culture matters; younger cultures (24–48 hours old) are more responsive to pH changes than older ones, which may have already entered a stationary phase with reduced sporulation capacity.
From a persuasive standpoint, controlling pH levels is not just a technical detail but a critical factor in optimizing yeast sporulation for both industrial and scientific applications. For homebrewers, monitoring pH with test strips or digital meters can ensure consistent results, while biotechnologists can use pH manipulation to enhance spore yield in bioprocessing. However, caution is advised: abrupt pH shifts can stress yeast cells, leading to incomplete sporulation or cell death. Gradual adjustments, such as changing the pH by no more than 0.5 units per hour, are recommended to minimize stress.
In conclusion, pH levels act as a regulatory switch for yeast sporulation speed, offering a practical lever for controlling this process. By understanding the optimal pH ranges for specific yeast strains and adjusting conditions methodically, one can significantly influence the timing and success of spore development. Whether in a brewery, lab, or kitchen, mastering pH control is key to harnessing the full potential of yeast sporulation.
Exploring the Surprising Similarities Between Spores and Gymnosperm Seeds
You may want to see also
Explore related products

Effect of Oxygen Levels on Yeast Spores
Yeast spores, or ascospores, are remarkably resilient structures that can survive harsh conditions, but their development is significantly influenced by environmental factors, particularly oxygen levels. Oxygen plays a dual role in this process, acting as both a catalyst and a potential inhibitor. In aerobic conditions, yeast cells typically thrive and reproduce through budding, but when it comes to spore formation, known as sporulation, oxygen's role becomes more nuanced. Sporulation is an energy-intensive process, and while oxygen is essential for the initial stages of spore development, its availability must be carefully regulated to ensure successful maturation.
The Oxygen Threshold: A Delicate Balance
Sporulation in yeast, such as *Saccharomyces cerevisiae*, is triggered by nutrient deprivation, particularly the lack of nitrogen. However, oxygen availability during this phase is critical. Research indicates that yeast spores require a minimum oxygen concentration of 0.5–1% for efficient sporulation. Below this threshold, the process is significantly delayed or halted altogether. Conversely, excessive oxygen levels (above 5%) can lead to oxidative stress, damaging cellular components and reducing spore viability. For optimal results, maintaining oxygen levels between 1–3% is recommended, ensuring a balance that supports metabolic activity without causing harm.
Practical Tips for Controlled Environments
In laboratory or industrial settings, controlling oxygen levels during yeast sporulation is essential for maximizing spore yield and quality. One effective method is using sealed fermentation vessels with controlled gas mixtures. For instance, a 2% oxygen environment can be achieved by flushing the vessel with a mixture of 2% oxygen and 98% nitrogen. Monitoring oxygen levels in real-time using sensors ensures consistency. Additionally, reducing agitation in the culture can minimize oxygen uptake, providing a more stable environment for spore development. For homebrewers or small-scale cultivators, using airtight containers with limited aeration can mimic these conditions, though precision may vary.
Comparative Analysis: Aerobic vs. Anaerobic Conditions
While aerobic conditions are necessary for sporulation initiation, the transition to anaerobic conditions during later stages can enhance spore resilience. Studies show that yeast spores developed under mild hypoxic conditions (0.5–1% oxygen) exhibit greater resistance to environmental stressors, such as heat and desiccation, compared to those formed in higher oxygen environments. This phenomenon is attributed to the activation of stress-response pathways, which fortify spore walls and metabolic reserves. However, prolonged anaerobic conditions during early sporulation stages can stall the process entirely, underscoring the need for precise oxygen management.
Takeaway: Oxygen as a Double-Edged Sword
Understanding the effect of oxygen levels on yeast spore development is crucial for optimizing sporulation efficiency and spore quality. While oxygen is indispensable for initiating the process, its concentration must be carefully calibrated to avoid oxidative damage or developmental stagnation. By maintaining oxygen levels within the 1–3% range and transitioning to hypoxic conditions during later stages, cultivators can enhance spore yield and durability. This knowledge not only benefits scientific research but also has practical applications in industries such as biotechnology, food production, and brewing, where yeast spores play a pivotal role.
Storing Mushroom Spores: Fridge or Not? A Complete Guide
You may want to see also

Comparison of Yeast Species Sporulation Rates
Yeast sporulation rates vary significantly across species, influenced by factors like nutrient availability, temperature, and genetic makeup. For instance, *Saccharomyces cerevisiae*, commonly used in baking and brewing, typically completes sporulation within 5–7 days under optimal conditions. This process involves meiosis and the formation of four haploid spores within an ascus. In contrast, *Schizosaccharomyces pombe*, a fission yeast, does not naturally sporulate, as it reproduces primarily through binary fission. Understanding these differences is crucial for industries relying on yeast, as sporulation can impact fermentation efficiency and product quality.
Analyzing sporulation rates reveals that environmental stressors often accelerate the process. For example, nutrient deprivation, such as a lack of nitrogen, triggers *S. cerevisiae* to enter sporulation as a survival mechanism. This response is regulated by the IME1 gene, which activates the meiotic pathway. In *Candida albicans*, a pathogenic yeast, sporulation (though rare) occurs under specific conditions like high temperatures or pH shifts, taking up to 10–14 days. This slower rate is attributed to its complex dimorphic life cycle, which includes both yeast and hyphal forms. Such variations highlight the adaptive strategies of different yeast species.
Practical applications of sporulation rates are evident in biotechnology and food production. For instance, optimizing sporulation in *S. cerevisiae* can enhance its resilience during fermentation, reducing the risk of batch failures in brewing. To achieve this, maintain a temperature of 25–30°C and ensure a carbon-to-nitrogen ratio of 5:1 in the growth medium. Conversely, inhibiting sporulation in pathogenic yeasts like *C. albicans* could be a therapeutic target, as spores are more resistant to antifungal agents. Researchers are exploring compounds like filastatin to disrupt hyphal formation, indirectly affecting sporulation potential.
A comparative study of *Kluyveromyces marxianus* and *S. cerevisiae* shows that *K. marxianus* sporulates faster, often within 3–4 days, due to its thermotolerance and rapid metabolism. This makes it a promising candidate for industrial applications requiring quick turnaround times, such as bioethanol production. However, its spores are less stable than those of *S. cerevisiae*, which can remain dormant for months. When selecting a yeast species for a specific process, consider both sporulation rate and spore viability to balance efficiency and longevity.
In conclusion, sporulation rates among yeast species are as diverse as their ecological roles. From the rapid sporulation of *K. marxianus* to the conditional sporulation of *C. albicans*, each species has evolved unique mechanisms to survive environmental challenges. By leveraging this knowledge, industries can optimize yeast performance, whether for food production, biotechnology, or medical research. Tailoring conditions to align with a species’ sporulation timeline ensures maximum efficiency and desired outcomes.
Hydrogen Peroxide's Effectiveness Against Tetanus Spores: Fact or Fiction?
You may want to see also
Frequently asked questions
Under optimal conditions (adequate temperature, moisture, and nutrients), yeast spores can germinate within 1 to 2 hours.
Yes, temperature significantly impacts development time. Yeast spores germinate fastest at temperatures between 25°C and 35°C (77°F to 95°F), while colder temperatures slow or halt the process.
Yes, yeast spores can remain dormant for extended periods, ranging from several months to years, depending on environmental conditions like dryness and low temperatures.
After germination, yeast cells can form visible colonies within 24 to 48 hours under favorable conditions, depending on the strain and growth medium.
Yes, spore development times vary among yeast species. For example, *Saccharomyces cerevisiae* (baker's yeast) germinates quickly, while other species like *Schizosaccharomyces* may take longer.



![One in a Mill Instant Dry Yeast | 1.1 LB (Pack Of 1) [IMPROVED] Fast Acting Self Rising Yeast for Baking Bread, Cake, Pizza Dough Crust | Kosher | Quick Rapid Rise Leavening Agent for Pastries](https://m.media-amazon.com/images/I/71frk5lZTFL._AC_UL320_.jpg)



























